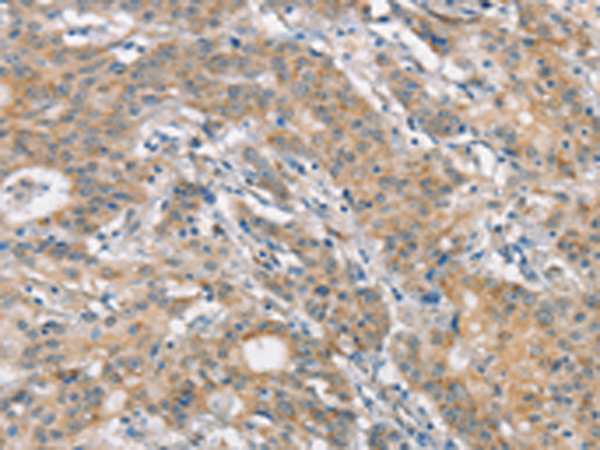
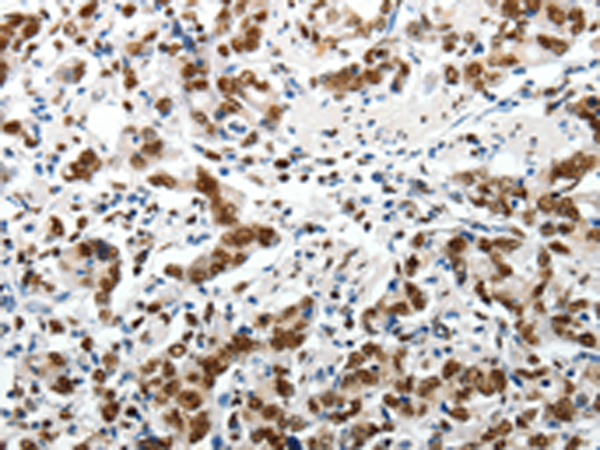

-
分类: 科研抗体货号: P11202别名: CRC18; CRCR1; MRMV1; IGDCC1应用: IHC反应种属: Human, Mouse, Rat
-
分类: 科研抗体货号: P11185别名: ARP2; HARP应用: WB,IHC反应种属: Human, Mouse
-
分类: 科研抗体货号: P11164别名: ACF1; WALp1; hACF1; WCRF180应用: IHC反应种属: Human, Mouse
-
分类: 科研抗体货号: P11201别名:应用: IHC反应种属: Human, Mouse, Rat
-
分类: 科研抗体货号: P11183别名: ANHU; SERPINA8应用: WB,IHC反应种属: Human, Mouse, Rat
-
分类: 科研抗体货号: P11161别名: TARSH; NESHBP应用: IHC反应种属: Human
-
分类: 科研抗体货号: P11200别名: BR; GPIa; CD49B; HPA-5; VLA-2; VLAA2应用: WB,IHC反应种属: Human
-
分类: 科研抗体货号: P11182别名: MIF; MIS应用: IHC反应种属: Human, Mouse, Rat
-
分类: 科研抗体货号: P11159别名: BSEP; PGY4; SPGP; ABC16; BRIC2; PFIC2; PFIC-2应用: IHC反应种属: Human, Mouse, Rat
-
分类: 科研抗体货号: P11199别名: PBT; SCFR; C-Kit; CD117应用: IHC反应种属: Human, Mouse

鄂公网安备42018502007531号
鄂公网安备42018502007531号

